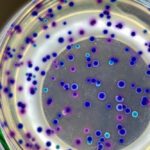
Study indicates marine plastic pollution as a breeding ground for disease-causing bacteria

Don’t blame the newts? Challenging the false dichotomy of nature vs the economy
There was widespread misinformation blaming nature as a blocker to growth in the run up to the Chancellor’s speech last week, writes Joe Keegan,...
Hidden threats to soil apparent from sewage sludge research
Recent research from The James Hutton Institute suggests that hidden threats from the agricultural use of contaminated sewage sludge could be contributing to already...
Ice-repelling secrets of polar bear fur
Polar bear fur’s natural ability to resist ice formation could pave the way for safer, more sustainable solutions to prevent ice buildup across industries...
Study indicates marine plastic pollution as a breeding ground for disease-causing bacteria
A new study reveals - seemingly for the first time - that particle type affects colonization, enrichment and spread of both antimicrobial-resistant and pathogenic...
Comment: PM’s ridicule of fish protection at Hinkley is no laughing matter
A statement issued by Mark Lloyd, Chief Executive of the Rivers Trust on 24 January.
It is very disappointing that the Prime Minister was so...
A new atlas maps the water flea’s world
A new online tool will help researchers to study the impact of pollution on Daphnia or water fleas - tiny freshwater crustaceans that are...
AI chatbot tool helps explore issues around antimicrobial resistance
A prototype AI chatbot tool has been developed to help pull together vital human, animal and environmental health information to support the global response...
£3m grant to assist solving “long-standing biological enigma” of magnetoreception
A team of researchers from the UK has been awarded £3 million by Wellcome to attempt to understand how animals are able to detect...
Genomic analysis reveals milestones in evolution of brown algae
A study from South Korea has revealed the evolutionary journey of brown algae through genomic analysis, with potential opportunities for aquaculture and developing sustainable...
Faltering progress with BNG could be improved with more time, people and data, suggests...
Early data released from a survey of over 100 professionals working in the ecology and environmental management sector in England has seemingly shown that...
Blinded by the light: the effects of urban lighting on beach bugs
A new method for examining the effects of Artificial Light at Night (ALAN) seemingly reveals severe and lasting damage to small coastal creatures.
An...
Nature-friendly planning reform needed as over half of English Local Authorities missed legal deadline...
New research, released today (13 December) by Wildlife and Countryside Link, reveals that overstretched and under-resourced English Local Authorities have been struggling to meet...
Acoustic landscape monitoring suggested as a game-changer for biodiversity improvement
AgriSound team member Calum Pheby with "Polly".
What's described as the world's first fully automated acoustic 'panoramic' landscape monitoring system, which can report in...
Scottish University launches 55-acre biodiversity project
A 55-acre site close to Aberdeen is to become one of the largest biodiversity projects on a university campus in Scotland.
Robert Gordon University...
Exploring the effects of offshore wind farms on ocean life
An ambitious new project aims to explore the consequences of floating offshore wind farms (FLOW) on life throughout the marine food chain. The Marine...
Bee killing pesticides polluting the vast majority of English rivers
A new analysis of the latest official data from the Environment Agency has uncovered widespread river pollution linked to toxic neonicotinoid pesticides (neonics), known...
Climate impacts on European soils predicted by Manchester group
New research appears to reveal how tiny soil microbes are impacted by extreme weather events, offering new insights into the risks posed by climate...
New trade body code offers complete overview of invasive weed control factors
National trade body the Property Care Association has produced a 360° overview of all elements involved in the management of invasive weed control in...
Study measures link between chemicals and declining insect populations
Measuring exposure to over 1,000 different agrochemicals, researchers reported significant changes in behaviour and long-term survival of different insect populations in a new study...
DNA probes will be deployed in Antarctic krill project
A new project launched on 1 November aims to protect the Southern Ocean ecosystem by focusing on Antarctic krill, a keystone species. Rising ocean...